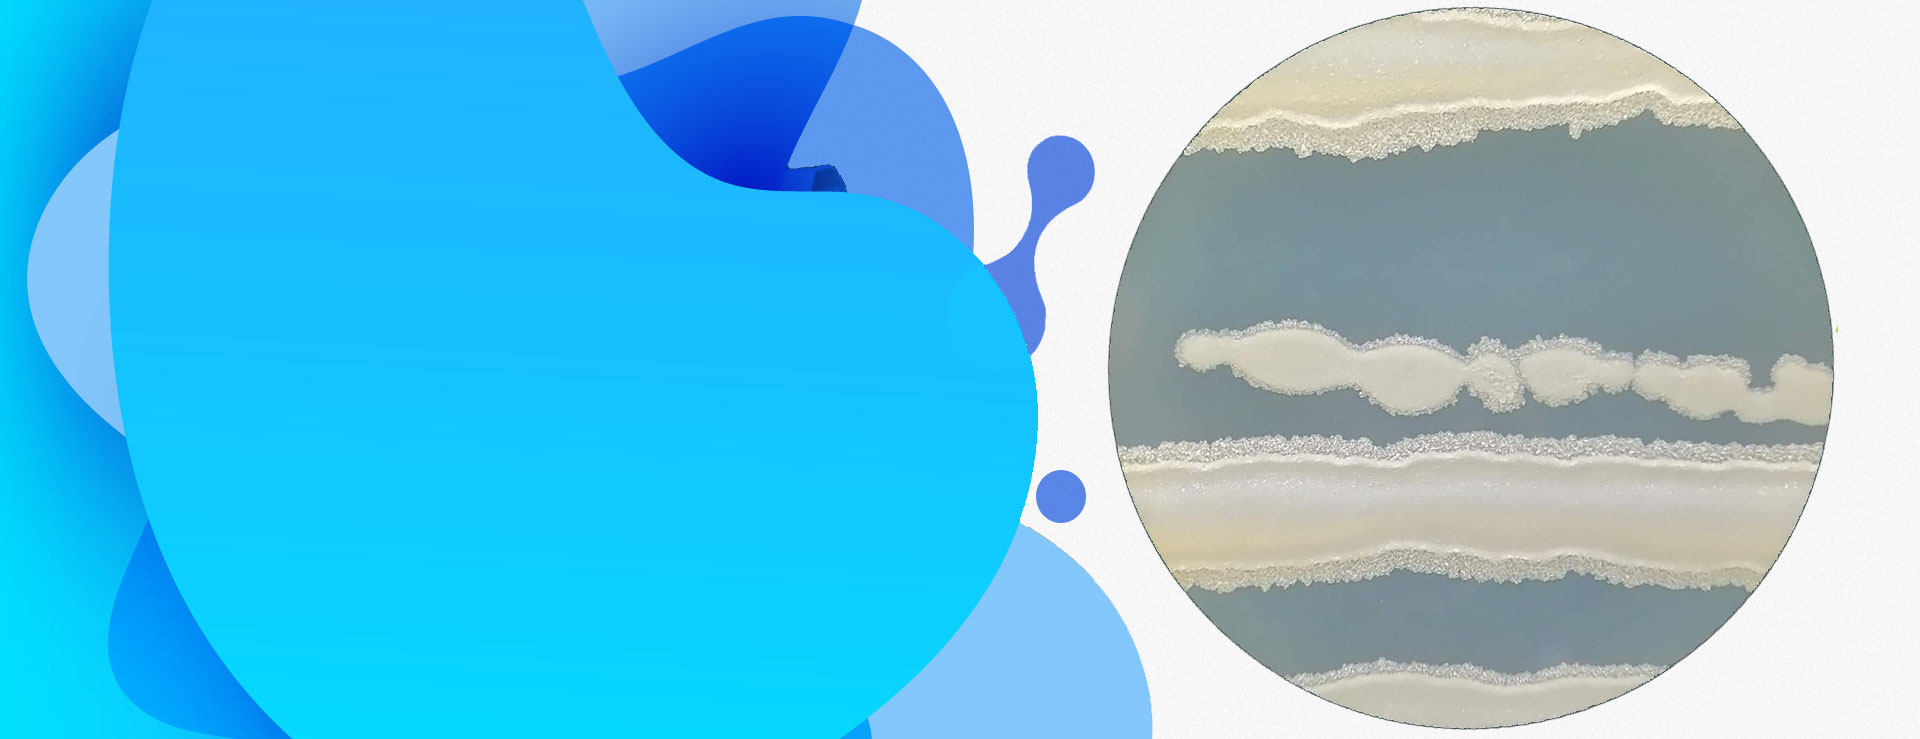

INBACTER es una compañía de base biotecnológica, spin-off académica de la Universidad de Antioquia, dedicada al desarrollo y producción de bioinsumos microbianos para agricultura, a partir de conocimientos avanzados en microbiología agrícola.
Con una ALTA CAPACIDAD DE INNOVACIÓN, desarrollamos tecnologías que aprovechan al máximo la diversidad microbiana en favor de una agricultura más sostenible, alimentos más sanos y un medio ambiente más limpio.
Nuestra Oferta
Si eres
Agricultor

- Desarrollo de productos de acuerdo con tus necesidades
- Montaje y acompañamiento para producción en finca
- Producción personalizada
Si eres
Productor-Comercializador de Agroinsumos

- Desarrollo de productos a la medida
- Montaje y acompañamiento para producción en tu empresa
- Producción para maquila
Nuestra Colección de Microorganismos
Producción deHONGOS BENÉFICOS EN FINCA

Buscamos masificar el uso de microorganismos benéficos para una producción agrícola más limpia y sostenible. Nuestro programa bandera es la PRODUCCIÓN DE HONGOS BIOCONTROLADORES Y BIOFERTILIZANTES EN SU PROPIA FINCA.